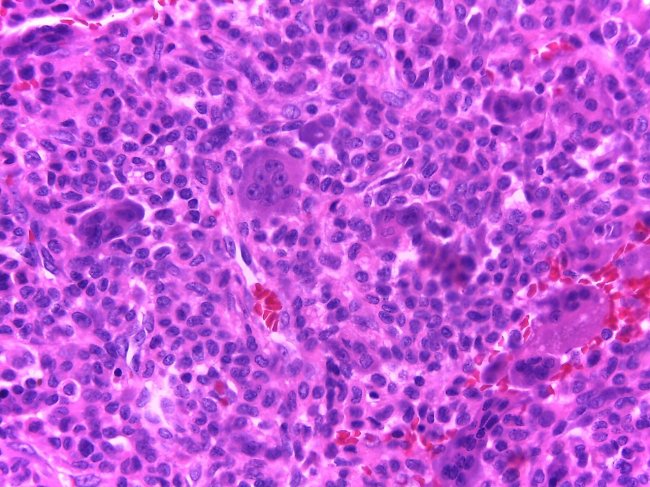

Unidade de Sarcomas e Tumores Ósseos
A Unidade de Tumores Ósseos e Partes Moles tem como missão o diagnóstico, tratamento e seguimento dos doentes com este tipo de cancro, habitualmente designado cancro dos ossos.
Os tumores ósseos e de partes moles, também designados como sarcomas, são raros e exigem uma abordagem especializada por profissionais com experiência nessa área.
Organização Clínica
Na CUF Oncologia, esta patologia é tratada de forma uniforme e transversal nos Hospitais e Clínicas CUF.
Esta unidade engloba uma equipa multidisciplinar de especialistas, composta por cirurgiões, ortopedistas, oncologistas médicos, radioncologistas, anatomo-patologistas, radiologistas, entre outros, na abordagem aos referidos tumores, que garantem os melhores resultados no tratamento e recuperação deste grupo de doenças.
Os nossos doentes e os seus cuidadores contam com um acompanhamento de grande proximidade, transmitindo confiança e esperança na recuperação da doença.
Ao seu dispor encontrará enfermeiros dedicados que o acompanham passo a passo para que se sinta sempre seguro e informado e uma equipa de gestores oncológicos, que facilitam todo o processo administrativo.
Coordenação:
Unidade de Tumores Ósseos e Partes Moles a Sul: Isabel Fernandes, Oncologista, e Hugo Vasques, Cirurgião Geral
Unidade de Tumores Ósseos e Partes Moles a Norte: José Dinis, Oncologista, Vítor Valente, Cirurgião Geral
Contacte um dos nossos Gestores Oncológicos para o guiar e acompanhar desde o primeiro momento.
Se preferir pode agendar uma consulta através da nossa linha gratuita.
As especialidades mais envolvidas no diagnóstico e tratamento dos sarcomas são:
- Ortopedia
- Cirugia Geral
- Oncologia Médica
- Anatomia Patológica
- Imagiologia
- Medicina Nuclear
- Radioterapia
Num doente com história clínica e exame clínico suspeitos de cancro do osso e de partes moles, devem ser feitos vários exames:
- Exames radiológicos: Radiografia convencional, ecografia, TC e/ou RMN;
- Biopsia óssea ou de partes moles guiada por imagem: colheita através de biopsia por agulha de fragmentos do tecido suspeito de osso com lesão.
- Exame histológico: Quando observado ao microscópio o material colhido através de uma biopsia é que é possível confirmar o diagnóstico de cancro.
Posteriormente ao diagnóstico é necessário fazer o estadiamento, para avaliar a extensão da doença.
O estadiamento é o processo pelo qual nos certificamos se as células do cancro se espalharam para outras estruturas próximas ou mais distantes. A informação obtida pelo processo de estadiamento determina o estadio da doença, fundamental para o tratamento poder ser planeado.
No caso do cancro do osso e partes moles podem ser pedidos, se ainda não foram:
- Exames de Imagiologia: Radiografia convencional, TAC e RMN;
- Exames de Medicina Nuclear: Cintigrafia óssea e PET.
A disseminação do cancro por várias outras partes do organismo pode dar-se de duas formas:
- Por contiguidade - invadindo através do tecido normal circundante;
- À distância - pelos sistemas circulatórios: sanguíneo ou linfático.
Os estadios do cancro têm implicação no tratamento podendo ser classificado da seguinte forma:
- Localizado: Não invadiu nem metastizou para fora dos tecidos onde se originou. Esta doença poderá ser removida cirurgicamente;
- Metastizado: A doença disseminou-se por outros órgãos.
Tendo em conta o estadiamento a equipa clínica multidisciplinar avaliará o melhor tratamento a seguir. Há alguns fatores iniciais que podem afectar o prognóstico desta doença e determinar as escolhas terapêuticas:
- A localização do tumor e se existe doença em mais do que um tecido;
- A dimensão do tumor;
- O tipo de tumor, baseado na avaliação pela Anatomia Patológica do tipo de células que lhe deu origem;
- A presença de doenças genéticas no doente;
- A extensão da doença, ou seja, se o tumor metastizou para outras partes do organismo.
Opções terapêuticas
Após reunião da equipa multidisciplinar, as opções de tratamento podem passar pela cirurgia, radioterapia e quimioterapia:
Doença localizada – a principal opção é a cirurgia, habitualmente complementada com radioterapia. Em determinadas situações, pode ser usada a quimioterapia antes ou depois da cirurgia.
Doença Metastizada – as localizações mais frequentes de metastização são os pulmões. Nestes casos as opções de tratamento incluem: cirurgia, quimioterapia e radioterapia, isolados ou em associação, adequados a cada situação clínica.
Sarcomas, osteosarcomas e condrosarcomas são alguns dos tipos de cancro dos ossos e tecidos moles. Conheça os fatores de risco, sintomas e a quem se dirigir no caso de suspeita de cancro.





